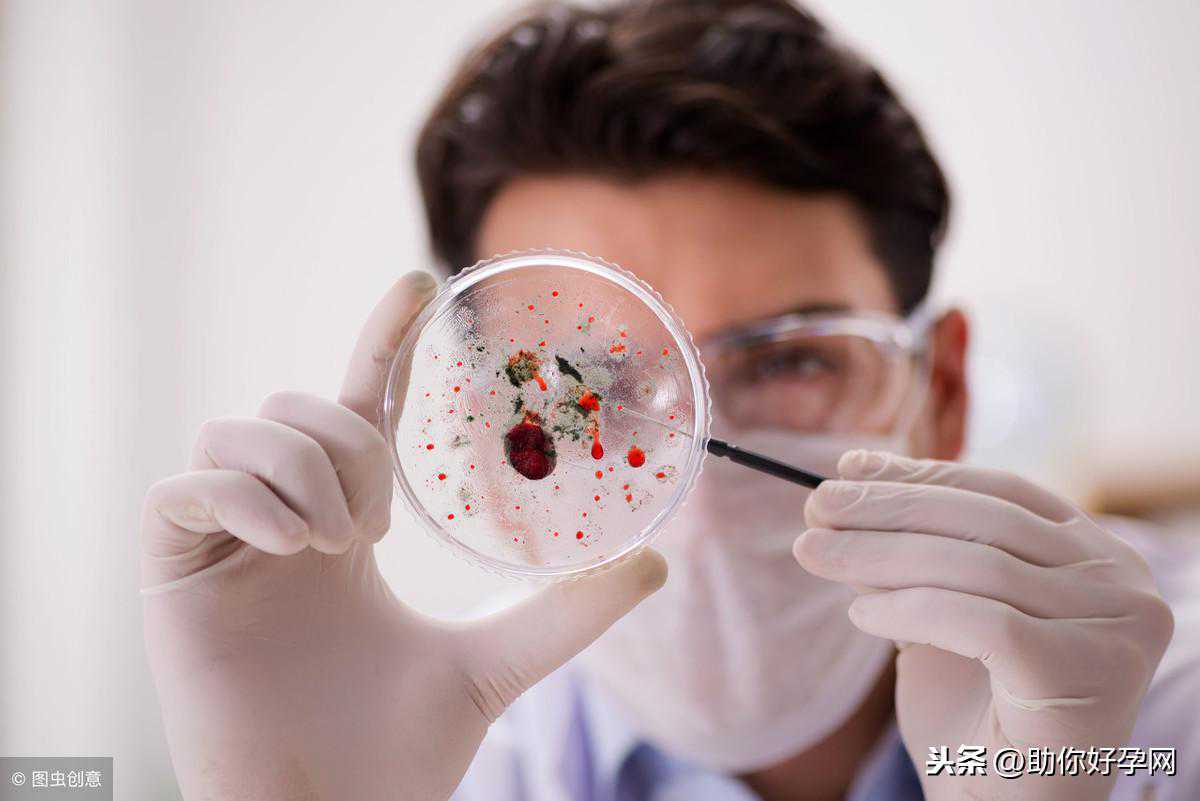

随着科学技术的发展,试管婴儿技术逐渐成熟。但是,试管婴儿这个词语对于大部分人来说还是比较生疏的。试管婴儿是体外受精-胚胎移植技术,简单来说是指采用人工方法让卵细胞和精子在体外受精,并进行早期胚胎发育,然后移植到母体子宫内发育而诞生的婴儿。
有些家庭通过正常的方法不能怀上孩子,会尝试试管婴儿。但是,所有的事情都是会有意外的情况发生。试管婴儿移植后也有一些原因可能会胎停,那么不妨提前了解一下是因为什么原因。

染色体异常
想必都知道,无论是精子还是卵子,只要携带基因遗传物质的染色体发生了异常,那么即使是形成了受精卵,胚胎也不能正常的发育。建议如果家族有遗传病史,应该在备孕前进行体检。预防染色体异常所导致的情况发生。
接触了有毒物质
在怀孕期间,胎儿容易受到外界因素的影响。例如空气中所含的有害物质。应该避免处于有害空气的空间内。比如:装修过的新家、办公室、实验室等地方。这些地方由于空气中含有有毒物质,不利于胎儿成长。如果,从事接触化学实验及有害物质接触的工作,在想要备孕之前应检查身体。
辐射影响
如果在准备怀孕的过程中需要拍摄X光片,一定要过一段时间再怀孕。手机最好能够使用耳机,不用的时候尽量放在较远的地方,避免辐射影响。
服用药物
怀孕期间,是避免用药的。但是,如果感觉有感冒的症状,不确定自己是否怀孕,怕服药会对胚胎产生不了影响。可以买试纸检测一下,确认一下是否怀孕。一般受精卵结合10天后,通过试纸就可以检测是否怀孕。

吸烟或酗酒
在准备怀孕期间,应该注意身体健康。如果妻子、丈夫有酗酒或者抽烟的情况,应该有计划的节制。
感染病毒
孕前一定要体检,不要到人群密集的地方,预防感染病毒。保证锻炼,保证饮食,增强自身抵抗力。
准妈妈患有慢性疾病
患有严重的糖尿病、高血压、心脏病、病毒性肝炎等严重慢性疾病的女性应该在病情稳定的情况下再考虑怀孕。应该遵照医嘱停服药物一段时间后再受孕。

试管婴儿移植后胎停的症状有哪些?怎么预防?
一般胚胎停止发育前会有少量的流血症状,早孕反应情况消失或减少。还有肚子增长停止。当然,由于个人体质不同,情况也不相同。还有的孕妈出现胎停情况没有征兆,突然腹痛,随后流产。
所以还是提醒准妈妈们一定要注意怀孕期间自己的身体状况。如果自己不确定什么原因,还是及时就医方为上策。想要了解更多关于孕期保胎、预防相关的内容,可以微信搜索我们的公众号:“助你好孕网”,近距离咨询保胎名医,了解保胎知识,让你少走弯路!









